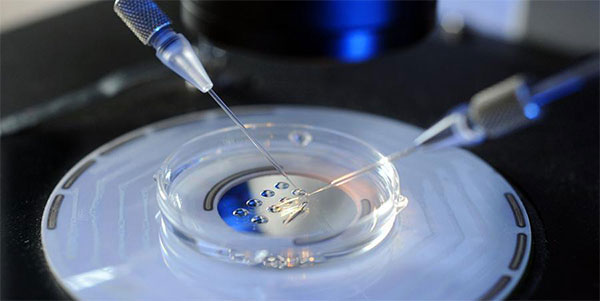

赴格鲁吉亚试管婴儿攻略分享,这6个流程步骤可做了解
- 试管婴儿百科
- 2025-03-01 10:19
目前来说,如果到海外做试管的话,考虑到性价比,那么到格鲁吉亚做试管婴儿是个不错的选择。不仅试管婴儿成功率高,而且关键是试管婴儿费用低廉,很适合中低资产家庭患者。本文分享赴格鲁吉亚做试管婴儿的攻略,详细介绍试管婴儿的6个流程步骤。
格鲁吉亚试管婴儿攻略介绍
格鲁吉亚试管婴儿攻略
一般来说,格鲁吉亚做试管婴儿攻略,主要有4个方面的内容,首先是预约试管婴儿机构、然后是交流患者不孕病情、然后是申请出国护照,最后是预定机票和酒店,具体内容如下:
去格鲁吉亚之前要预约试管机构
1、预约试管婴儿机构
提前选择好要做试管婴儿的医院,网络上有很多中介小心千万不要上当受骗了,可以先阅读下格鲁吉亚试管婴儿防骗指南;
2、交流不孕病情
跟格鲁吉亚医生交流自己的情况,不孕不育的病因有很多,有些是男方精子问题,有些事女方卵子的问题。不同的情况要选择不同的是婴儿技术,这一步是可以在国内完成的;
办理格鲁吉亚护照和签证
3、出国护照申请
申办格鲁吉亚护照有关手续,当事人须亲自填写《办理护照有关事项申请表》并到大使馆领事部办理。护照是你的国际身份证,但是前往一个国家的时候是需要被当地许可的,签证就是你的同性许可证,中国人去格鲁吉亚被拒签的概率无限趋近于零;
4、预定机票酒店
拿到出国护照后可以跟格鲁吉亚当地医院确定做试管婴儿的时间,然后开始预订格鲁吉亚往返机票和酒店。以上四步完成后就可以出发格鲁吉亚开始做试管婴儿啦,如果你不懂格语的话还可以考虑寻找一个格语翻译这样可以帮助更好的完成这次治疗之旅。
实际上各个国家做试管婴儿的流程都差不多,也包格鲁吉亚,而影响试管婴儿成功率的主要原因在于细节处理和医生专业程度。
格鲁吉亚试管婴儿的流程
格鲁吉亚试管婴儿流程包括术前检查、促排卵、取卵取精、胚胎移植、妊娠检查等,实际上出国做试管婴儿的流程与国内相差不大,只是前期会增加预约沟通、交流病情、申请出国护照以及预定机票和酒店,格鲁吉亚试管婴儿流程有六大步骤,具体内容如下:
术前检查是格鲁吉亚试管流程之一
1、术前检查
术前检查是做试管婴儿的第一步,一般医生会要求夫妻双方在女性月经第2-5天进行检查,由于试管婴儿术前检查并不是一次性检查完的,所以在进行常规项目检查时一定要听从医生的安排。前期的一些检查项目男性和女性都是不一样的,相对而言女性的检查项目会多很多,如性激素六项检查、内分泌全套、病毒四项等;
2、促排卵检查
完后医生在明确你身体的情况下,会初步制定适合患者的方案,一般促排降调方案主要分为长效长方案、短效长方案、短方案、微刺激方案等,不同的试管婴儿促排方案适应症不同。整个促排卵的时间因人而异,可能十几天也可能二十几天;
3、取卵取精
在监测到卵泡发育成熟后,就会进入到取卵流程,一般试管婴儿取卵和取精会同时进行。男性取精较为简单,女性取卵一般10分钟左右就完成了,很多女性都会对取卵环节非常恐惧,其实取卵过程并不痛,取卵时会进行麻醉,女性放松不要紧张即可;
胚胎培养至囊胚后送检PGS
4、胚胎培养
取卵取精结束后,医生会将卵子和取出的精子在培养皿进行体外受精,培养到第五天的囊胚会送检PGS,之后医生会根据PGS结果为您进行鲜胚移植或选择冷冻胚胎,之后再进行移植。期间要求调理好身体,可能需要进行一段时间的黄体支持及调理,准备以理想的身体和心理状态迎接囊胚移植。过程中相因生育顾问会给予您注射黄体酮的相关指导;
5、胚胎移植
一般会根据女性的身体情况个胚胎移植的方式来确实时间,移植的胚胎会分为鲜胚、冻胚和囊胚这三种,每种区别不同。囊胚移植前还要做PGS/PGD筛查,这个过程需要一段时间;
6、验血查hcg值
一般在胚胎移植后3到5天,胚胎就逐渐开始着床然后分泌hCG,等到胚胎移植14天后就可查血hCG测出是否妊娠,如果发现hCG升高则等到移植后28-30天时做一次阴道B超,能够看见妊娠囊和胚芽心搏,才能诊断临床妊娠。
在格鲁吉亚做试管婴儿的时候最好选择比较知名的医院,选择好点的医院,不仅试管婴儿成功率有保障,而且对患者的后期有着完善的服务指导。

发表评论